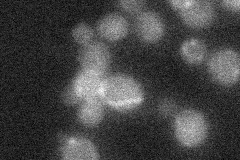
YOR093C
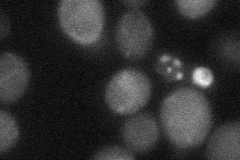
YOR093C

View description
Putative protein of unknown function; deletion causes sensitivity to unfolded protein response-inducing agents
Localization:
Intensity:
Fold change:
Significance:
-
C’ GFP library in SD

below threshold19.25 -
N' NOP1pr-GFP in SD

cytosol,bud30.7161 -
N' TEF2pr-mCherry in SD

cytosol,bud neck20.4773 -
N' NATIVEpr-GFP in SD
below threshold16.8468 -
N' TEF2pr-VC and Cyto-VN in SD
below threshold26.0336 -
C’ GFP library in SD+DTT

cytosol18.510.96No -
C’ GFP library in SD+H2O2

cytosol22.231.15No -
C’ GFP library in Starvation Media

cytosol18.50.96No -
C’ GFP library on the background of Pup2-DaMP

below threshold -
C’ GFP library on the background of CCT mutant

below threshold21.23431.10241No
